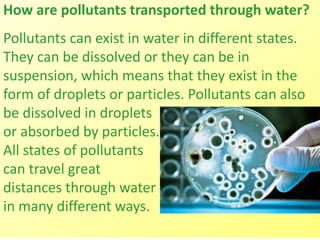
How are pollutants transported through water?
Pollutants can exist in water in different states.
They can be dissolved or they can be in
suspension, which means that they exist in the
form of droplets or particles. Pollutants can also
be dissolved in droplets
or absorbed by particles.
All states of pollutants
can travel great
distances through water
in many different ways.

This document discusses water pollution and its causes. It explains that water pollution occurs when large amounts of pollutants are added to water bodies, harming water quality and aquatic life. Pollutants can come from point sources like pipes directly releasing waste, or non-point sources like farm runoff carrying fertilizers and pesticides. Various types of pollution are described like toxic, organic, and thermal pollution. Specific sources of pollution are also outlined, such as runoff from agricultural lands, industrial waste, and household sewage. The document encourages actions like proper waste disposal and use of environmentally-safe chemicals to help reduce water pollution.





![Types of Water Pollution
1] Toxic Substance -- A toxic substance is a chemical
pollutant that is not a naturally occurring substance in
aquatic ecosystems. The greatest contributors to toxic
pollution are herbicides, pesticides and industrial
compounds.](https://image.slidesharecdn.com/gem-ppt-27-stopwaterpollution-160504075309/85/Gem-ppt-27-stop-water-pollution-6-320.jpg)
![2] Organic Substance
Organic pollution occurs when an excess of organic matter,
such as manure or sewage, enters the water. When organic
matter increases in a pond, the number of decomposers will
increase. These decomposers grow rapidly and use a great
deal of oxygen during their
growth. This leads to a
depletion of oxygen as the
decomposition process occurs.
A lack of oxygen can kill aquatic
organisms. As the aquatic
organisms die, they are broken
down by decomposers which leads to further depletion of the
oxygen levels.](https://image.slidesharecdn.com/gem-ppt-27-stopwaterpollution-160504075309/85/Gem-ppt-27-stop-water-pollution-7-320.jpg)
![3] Thermal Pollution
Thermal pollution can
occur when water is
used as a coolant near
a power or industrial
plant and then is
returned to the aquatic
environment at a higher temperature than it was
originally. Thermal pollution can lead to a decrease in
the dissolved oxygen level in the water while also
increasing the biological demand of aquatic
organisms for oxygen.](https://image.slidesharecdn.com/gem-ppt-27-stopwaterpollution-160504075309/85/Gem-ppt-27-stop-water-pollution-8-320.jpg)
![4] Ecological Pollution
Ecological pollution takes place when chemical pollution,
organic pollution or thermal pollution are caused by nature
rather than by human activity. An example of ecological
pollution would be an increased rate of siltation of a
waterway after a landslide which would increase the amount
of sediments in runoff water.
Another example would be
when a large animal, such as
a deer, drowns in a flood and
a large amount of organic
material is added to the water
as a result. Major geological
events such as a volcano eruption might also be sources of
ecological pollution.](https://image.slidesharecdn.com/gem-ppt-27-stopwaterpollution-160504075309/85/Gem-ppt-27-stop-water-pollution-9-320.jpg)
![Specific Sources of Water Pollution
1] Farming
Farms often use large amounts of herbicides and pesticides,
both of which are toxic pollutants. These substances are
particularly dangerous to life in rivers, streams and lakes,
where toxic substances can
build up over a period of time.
Farms also frequently use large
amounts of chemical fertilizers
that are washed into the
waterways and damage the water
supply and the life within it.
Fertilizers can increase the amounts of nitrates and
phosphates in the water, which can lead to the process of
eutrophication.](https://image.slidesharecdn.com/gem-ppt-27-stopwaterpollution-160504075309/85/Gem-ppt-27-stop-water-pollution-10-320.jpg)
![2] Business
Clearing of land can lead to erosion of soil into the river.
Waste and sewage generated by industry can get into the
water supply, introducing large organic pollutants into the
ecosystem.
Many industrial and power
plants use rivers, streams and
lakes to dispose of waste heat.
The resulting hot water can
cause thermal pollution.
Thermal pollution can have a
disastrous effect on life in an aquatic ecosystem as
temperature increases decrease the amount of oxygen in the
water, thereby reducing the number of animals that can
survive there.](https://image.slidesharecdn.com/gem-ppt-27-stopwaterpollution-160504075309/85/Gem-ppt-27-stop-water-pollution-11-320.jpg)
![3] Homes
Sewage generated by houses or runoff from septic tanks into
nearby waterways, introduce organic pollutants that can cause
eutrophication.
Fertilizers, herbicides and
pesticides used for lawn care
can runoff and contaminate
the waterway.
As with agricultural fertilizers,
home fertilizers can lead to the
eutrophication of lakes and rivers.
Improper disposal of hazardous chemicals down the drain
introduce toxic materials into to the ecosystem, contaminating the
water supplies in a way that can harm aquatic organisms.
Leaks of oil and antifreeze from a car on a driveway can be washed
off by the rain into nearby waterways, polluting it.](https://image.slidesharecdn.com/gem-ppt-27-stopwaterpollution-160504075309/85/Gem-ppt-27-stop-water-pollution-12-320.jpg)

![1] Never throw rubbish away anyhow. Always
look for the correct waste bin. If there is none
around, please take it home and put it in your
trash can. This includes places like the beach,
riverside and water bodies.](https://image.slidesharecdn.com/gem-ppt-27-stopwaterpollution-160504075309/85/Gem-ppt-27-stop-water-pollution-16-320.jpg)
![2] Do not throw
chemicals, oils, paints
and medicines
down the sink drain,
or the toilet. In many
cities, your local
environment office
can help with the disposal of medicines
and chemicals. Check with your local
authorities if there is a chemical disposal
plan for local residents.](https://image.slidesharecdn.com/gem-ppt-27-stopwaterpollution-160504075309/85/Gem-ppt-27-stop-water-pollution-17-320.jpg)
![3] Buy more environmentally safe
cleaning liquids for use at home and
other public places. They are less
dangerous to the environment.](https://image.slidesharecdn.com/gem-ppt-27-stopwaterpollution-160504075309/85/Gem-ppt-27-stop-water-pollution-18-320.jpg)
![4] If you use chemicals and pesticides for your
gardens and farms, be mindful not to overuse
pesticides and fertilizers. This will reduce
runoffs of the chemical into nearby water
sources. Start looking at options of
composting and using organic manure instead.](https://image.slidesharecdn.com/gem-ppt-27-stopwaterpollution-160504075309/85/Gem-ppt-27-stop-water-pollution-19-320.jpg)
![5] If you live close to a water body, try to
plant lots of trees and flowers around your
home, so that when it rains, chemicals
from your home does not easily drain into
the water.](https://image.slidesharecdn.com/gem-ppt-27-stopwaterpollution-160504075309/85/Gem-ppt-27-stop-water-pollution-20-320.jpg)





